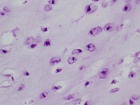
Zoom image: Cell stain

Case 1
54 year old male with two year history of increasing swelling in left flank
Upcoming Events
Import medical school events to your Exchange, Gmail, iPhone or iPod calendar. Customize your calendar by selecting different event categories and receive automatic reminders of the school events that matter most to you.